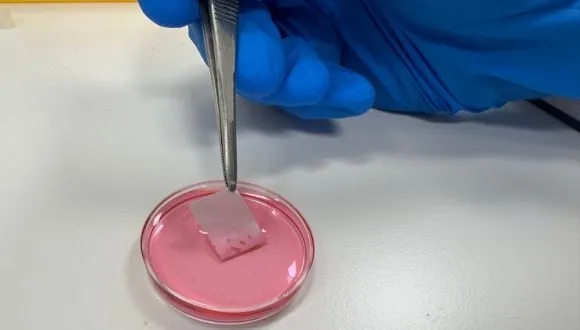

Medicine & Health





Breakthrough at TAU: Blocking One Protein Could Prevent Food Allergy Disease
August 11, 2025



The Israeli dentist who helped identify bodies ravaged by Hamas’ October 7 terrorist attack
June 20, 2025

Innovative Technology from Tel Aviv University researchers can double IVF Success Rates
February 9, 2025
















